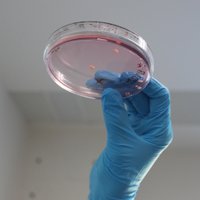
Shcheglovitov Lab (@shcheglovitov) 's Twitter Profile Photo

Alex Shcheglovitov 🇺🇦
@alexshcheglovit
Associate Professor @shcheglovitov @UUNeurobiology @UUtah studying human 🧠 development in health and disease using #iPSC & #organoid
ID: 464404305
http://shcheglovitov-lab.utah.edu 15-01-2012 05:50:09
471 Tweet
582 Followers
549 Following

Way to go H M Arif Ullah, PhD !!👏👏








This is a cool one. We leveraged single cell analysis and in vivo calcium imaging to examine how ASD risk gene Shank3 alters the activity of heterogeneous cell populations during anxiety. Congrats to Hailee,Damhyeon Kwak , and Prakash! biorxiv.org/content/10.110…







